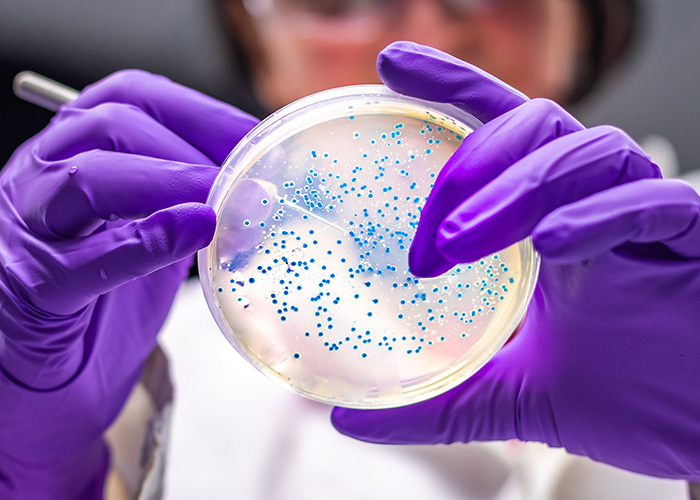
Microbioma geniturinário

A alta incidência de doenças infecciosas como a dengue tem, ao longo dos anos, impulsionado o desenvolvimento de dispositivos de biossensoriamento (biossensores) mais eficientes. Entre as inovações, pesquisadores do Departamento de Física da Faculdade de Filosofia, Ciências e Letras de Ribeirão Preto da Universidade de São Paulo divulgaram a criação de um novo método […]
Mês: setembro 2025
Benefícios do
Doce, de textura macia e nutritivo, o caqui é originário da Ásia, especialmente da China e Japão, que se adaptou muito bem ao clima brasileiro. Considerado um alimento versátil, pode ser consumido in natura e no preparo de vitaminas, sobremesas, saladas, geleias e até em pratos salgados. O caqui é rico em antioxidantes, vitaminas […]
Acolhimento aos
Complicações durante o pré-natal ou a necessidade de proteger a saúde da mãe e do bebê podem levar a um parto pré-termo, ou seja, antes de 37 semanas de gestação. Nestes casos, a experiência de ter um bebê prematuro é uma jornada única, emotiva e desafiadora. Mais do que o cuidado com os bebês, […]
Avanços no
A leucemia é um tipo de câncer que afeta a medula óssea, local responsável pela produção das células sanguíneas como leucócitos, plaquetas e hemácias. A doença ocorre quando as células-tronco sofrem alterações genéticas e passam a produzir células imaturas, conhecidas como blastos, que se multiplicam descontroladamente. Esse processo prejudica o desenvolvimento das células saudáveis. […]
Traumas da infância e
Um estudo conduzido por pesquisadores do Brasil e do Reino Unido apontou uma associação entre traumas na infância e o desenvolvimento de transtornos psiquiátricos na adolescência, sobretudo em países de baixa e média renda. Entre os eventos analisados estão acidentes graves, desastres naturais, violência doméstica, perda de um dos pais e abuso físico e/ou […]
Coito programado é
Engravidar pode ser uma jornada desafiadora para muitas mulheres. Fatores como idade, distúrbios hormonais e qualidade do esperma podem impactar diretamente a fertilidade. Estimativas da Organização Mundial da Saúde (OMS) apontam que entre 10% e 15% dos casais em idade reprodutiva enfrentam dificuldades para conceber após um ano de tentativas. Entre as possibilidades de […]
Uma microbiota exclusiva
O microbioma humano impacta significativamente na fisiopatologia. Estudos recentes indicam que diversas comunidades microbianas desempenham papéis cruciais na manutenção da homeostase do hospedeiro e podem até contribuir para o desenvolvimento do câncer. Evidências atuais sugerem que indivíduos saudáveis possuem uma presença microbiana substancial no microbioma geniturinário, que pode ser influenciada por vários fatores como […]
Nanotecnologia intensifica
A cúrcuma é uma planta da família Zingiberaceae utilizada como condimento e corante. Além do uso culinário, essa planta originária do continente asiático tem sido alvo de inúmeras pesquisas devido ao seu principal composto bioativo: a curcumina. Apesar dos efeitos anti-inflamatório e antioxidante conhecidos, o potencial terapêutico da curcumina para prevenir e tratar doenças […]
Probiótico LcS faz
Em 2012, a Yakult Honsha (matriz localizada em Tóquio) e a Agência de Exploração Aeroespacial do Japão (JAXA) iniciaram uma pesquisa conjunta. Os pesquisadores pretendem investigar o efeito do consumo do probiótico Lactobacillus casei Shirota (LcS) sobre o sistema imunológico e a microbiota intestinal fora da Terra. Por ser uma estirpe probiótica muito bem […]